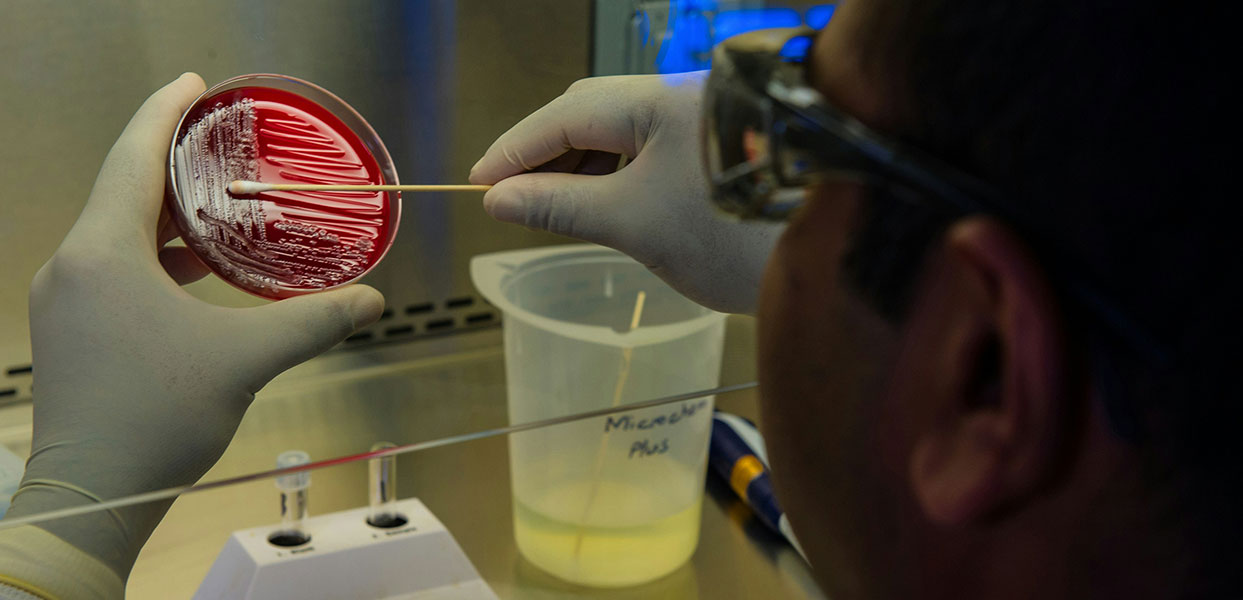

December Webinar: Leveraging AI Agents for Accuracy and Automation in Food Quality, Safety, and Compliance
December 10, 2025
1pm to 2 pm
Online

November Webinar: Procurement as the First Line of Defense Against Food Fraud
November 20, 2025
11 am to 12 pm
Online

October Webinar: Gemba 101 - From Boots to Brilliance: Leading Food Safety on the Factory Floor
October 30, 2025
1 pm to 2 pm
Online

OFPA 68th Annual Food Safety Conference: 2 Day Event (Sep 30 & Oct 1, 2025):
September 30, 2025
Millennium Gardens Banquet Centre
20 Polonia Ave, Unit 100
Brampton, ON
L6Y 5W8

June Webinar: Building the Foundation: Achieving Traceability and Transparency in the food supply chain
June 18, 2025
2 pm to 3 pm
Online

May Webinar: Smart Compliance for Food Companies: Lean Data Management & Proportional Quality Systems
May 29, 2025
11 am to 12 pm
Online
April Webinar: Environmental Monitoring in the Food Industry: Advancing Hygiene with Innovative ATP Testing
April 17, 2025
11 am to 12 pm
Online

March Webinar: Allergen Management
March 20, 2025
11 am to 12 pm
Online

February Webinar: Paper to Digital: Streamlining Food Safety Management
February 20, 2025
2 pm to 3 pm
Online

December Webinar: Best practices for manufacturing gluten-free products
December 11, 2024
12 pm to 1 pm
Online

November Webinar: AMA (Ask Me Anything) with Siarl Dixon
November 25, 2024
12 pm to 1 pm
Online

October Webinar: Empowering Foodservice: Meeting Consumer Needs through Effective Food Allergy Solutions
October 31, 2024
11 am to 12 pm
Online

OFPA 67th Annual Food Safety Conference: 2 Day Event (Sep 30 & Oct 1, 2024):
September 30, 2024
Bellvue Manor
8083 Jane St
Concord, ON
L4K 2M7

September Webinar: Navigating Government Grants and Funding Complexities: The Right Combination for Successful Projects
September 12, 2024
1 pm to 2 pm
Online

August Webinar: Cyber Resilience for Food Safety: Safeguarding Critical Infrastructure – Cyber Attack Simulation
August 20, 2024
2 pm to 3 pm
Online

July Webinar: Cleaning and Sanitation Validation: Prospects and Bottlenecks
July 29, 2024
2 pm to 3 pm
Online

June Webinar: Practical Considerations in Food Safety Digitization
June 24, 2024
2 pm to 3 pm
Online

May Webinar: Genomics 101: Applications in the Food Industry
May 23, 2024
10 am to 11 am
Online

April Webinar: Embracing Proactivity: Effectively Managing Supplier Risks and Ingredient Hazards
April 24, 2024
11 am to 12 pm
Online

March Webinar: Food Recall Strategies: Challenges and Solutions
March 28, 2024
1 pm to 2 pm
Online

February Webinar: The Common Principles of QA & Product Safety Between Food and Edibles
February 12, 2024
1 pm to 2 pm
Online

January Webinar: Enhancing Guidance for Food Allergen Management in Canada including a Risk-based Approach for the Application of Precautionary Allergen Labelling
January 23, 2024
1:00 pm - 2:00 pm
Online

December Webinar: Genomic Control Approaches for Salmonella in Dry Foods
December 1, 2023
10:00am - 11:00am
Online

2023 Fall Food Safety Symposium and 66th Annual General Meeting
November 16, 2023
8:30am - 5:00pm
Chateau Les Jardins
8440 ON-27
Woodbridge, ON
L4H 0A7

November Webinar: A Culture of Food Safety & Quality at McCain Foods Ltd
November 14, 2023
2:00pm - 3:00pm
Online

October Webinar: Bridging the Gap Between Students, Graduates, and Employers
October 12, 2023
11:00am - 12:00pm
Online

September Webinar: Learn About SR&ED & How To Qualify, & Next Steps
October 5, 2023
1:00pm - 2:00 pm
Online

2023 OFPA Social Networking Mixer
September 14, 2023
5:00pm - 9:00pm
Lost Craft Brewery
837 Runnymede Rd
Toronto, ON
M6N 3V8

August Webinar: Unlocking Financial Support & Growth Potential
August 10, 2023
10:00am - 11:00am
Online

2023 International Association for Food Protection (IAFP) Annual Meeting
July 16, 2023
Metro Toronto Convention Centre
255 Front St W, Toronto, ON

July Webinar: Building Foundational Elements for Sustainable Food Safety Management System
July 13, 2023
3:00pm - 4:00pm
Online

June Webinar: Allergen Control – Challenges, Perspectives & Solutions
June 1, 2023
11:00am - 12:00pm
Online

May Webinar: Building Food Safety Culture within Food Service and Retail
May 5, 2023
11:00am - 12:00pm
Online

April Webinar: How To Get The Most Out Of Your Third Party Certification Audit
April 28, 2023
11:00am - 12:00pm
Online

2023 OFPA Spring Technical Meeting & Clive Kingsbury Video Competition
April 21, 2023
7:00am - 4:00pm
Centennial College Event Centre
937 Progress Ave
Scarborough, ON
M1G 3T8

2022 Fall Food Safety Symposium & 65th Annual General Meeting – Event Photo’s Update
November 15, 2022
8:30am - 5:00pm
Corporate Event Centre
5110 Creekbank Rd
Mississauga, ON
L4W 0A1

2022 OFPA Social Networking Mixer Update Event Photos
September 22, 2022
5:00pm - 9:00pm
Cedar Brae Golf Club
Scarborough, ON
M1X 1N6

2022 OFPA Spring Technical Meeting & Clive Kingsbury Video Competition
April 14, 2022
7:00am - 4:10pm
Centennial College Event Centre
937 Progress Ave
Scarborough, ON
M1G 3T8

GFSR Virtual Conference – The Age of Modern Food Safety Training
February 24, 2022
12:00pm - 17:00pm
Online
